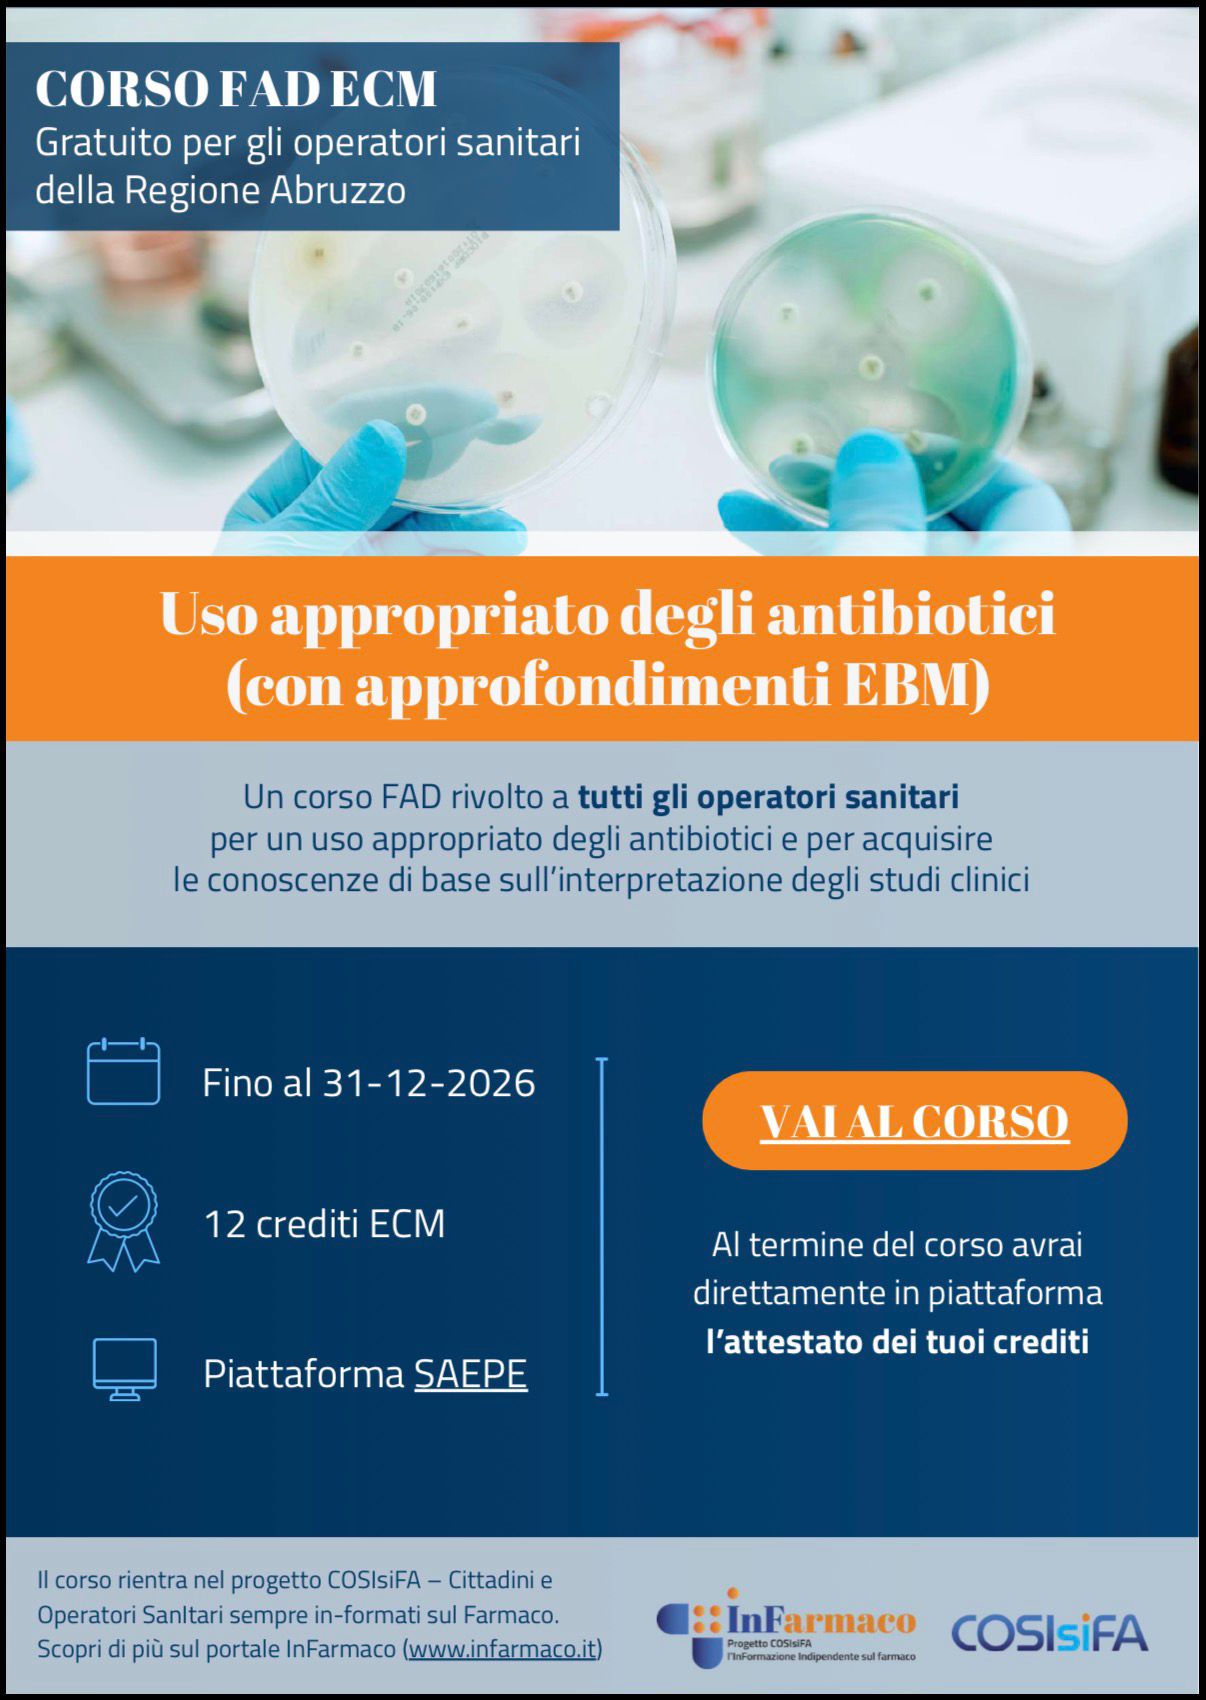
Antibiotici opiteramo

La Regione Abruzzo ha aderito al progetto nazionale AIFA COSIsiFA – Cittadini e Operatori Sanitari Sempre In-formati sul Farmaco, promosso dal Servizio Farmaceutico Regionale e coordinato dal Centro Regionale di Farmacovigilanza, finalizzato a promuovere l’uso appropriato e sicuro dei farmaci.
Nell’ambito del progetto sono disponibili due corsi FAD ECM gratuiti in modalità asincrona, rivolti a tutti gli operatori sanitari della Regione Abruzzo:
“Uso appropriato degli antibiotici (con approfondimenti EBM)” (12 crediti ECM)
“Revisione della terapia e riduzione dei farmaci nell’anziano” (14 crediti ECM).

I corsi sono accreditati fino al 31 dicembre 2026 e fruibili tramite la piattaforma SAEPE.
Modalità di iscrizione
• collegarsi al sito www.saepe.it
• cliccare su “Accedi” se già registrati, oppure su “Registrati” per creare un nuovo account
• completata la registrazione, si riceverà una mail automatica con le credenziali di accesso
• accedere in piattaforma e selezionare il corso di interesse
Al termine di ciascun corso, l’attestato ECM sarà disponibile direttamente online.
Si invita alla massima partecipazione e diffusione dell’iniziativa, considerata l’elevata rilevanza dei contenuti formativi proposti per la pratica clinico-assistenziale.